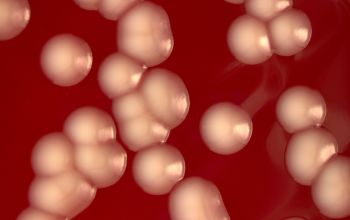

Sphingobacterium multivorum
-
General information
General information
Sphingobacterium species are capable of behaving as an opportunistic pathogen and producing severe infection in compromised patients.
Taxonomy
Family: Sphingobacteriaceae
Formerly: Flavobacterium
Natural habitat
In the environment, in food products, in an aqueous environment of a hospital, such as; the sink, incubators, water from the tap, hemodialysis systems and all kinds of aqueous solutions.
Does not belong to the normal flora of the human being.
Clinical significance
They are rarely involved in human infections. Two species S.multivorum and S. spiritivorum have occasionally been associated with bacteremia, peritonitis and chronic respiratory infections in patients with severe underlying conditions.
-
Gram stain
Gram-negative rods.
-
Culture characteristics
-
Obligate Aerobic
BA: colonies are medium sized, convex, smooth, opaque, they become yellow after several days at room temperature.
McConkey: growth, non lactose fermenter
BBAØ: no growth
-
-
Characteristics
-
References
James Versalovic et al.(2011) Manual of Clinical Microbiology 10th Edition
Karen C. Carrol et al (2019) Manual of Clinical Microbiology, 12th Edition